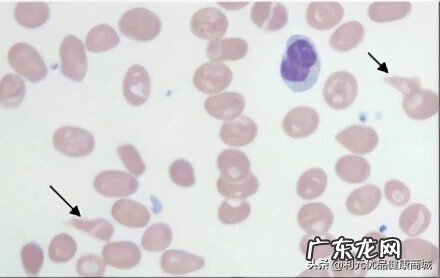
维生素b12哪些食物最多 维生素b12的作用和功效

二是维护神经髓鞘的代谢与功能 。缺乏维生素B12时,可引起神经障碍、脊髓变性,并可引起严重的精神症状 。维生素B12缺乏可导致周围神经炎 。小孩缺乏维生素B12的早期表现是情绪异常、表情呆滞、反应迟钝,最后导致贫血 。
三是促进红细胞的发育和成熟 。将甲基丙二酰辅酶A转化成琥珀酰辅酶A,参与三羧酸循环,其中琥珀酰辅酶A与血红素的合成有关 。
四是维生素B12还参与脱氧核酸(DNA)的合成,脂肪、碳水化合物及蛋白质的代谢,增加核酸与蛋白质的合成 。
病理
维生素b12和叶酸缺乏,胸腺嘧啶核苷酸减少,DNA合成速度减慢,而细胞内尿嘧啶脱氧核苷酸(dUMP)和脱氧三磷酸尿苷(dUTP)增多 。胸腺嘧啶脱氧核苷三磷酸(dTTP)减少,使尿嘧啶掺合入DNA,使DNA呈片段状,DNA复制减慢,核分裂时间延长(S期和G1期延长),故细胞核比正常大,核染色质呈疏松点网状,缺乏浓集现象,而胞质内RNA及蛋白质合成并无明显障碍 。随着核分裂延迟和合成量增多,形成胞体巨大,核浆发育不同步,核染色质疏松,所谓“老浆幼核”改变的巨型血细胞 。巨型改变以幼红细胞系列最显著,具特征性,称巨幼红细胞系列 。细胞形态的巨型改变也见于粒细胞、巨核细胞系列,甚至某些增殖性体细胞 。该巨幼红细胞易在骨髓内破坏,出现无效性红细胞生成 。最终导致红细胞数量不足,表现贫血症状 。
缺乏症状
文章插图
维生素B12缺乏导致恶性贫血(3张)
⒈恶性贫血(红血球不足)
⒉月经不调
⒊眼睛及皮肤发黄,皮肤出现局部(很小)红肿(不疼不痒)并伴随蜕皮;
⒋恶心,食欲不振,体重减轻
⒌唇、舌及牙龈发白,牙龈出血
⒍头痛,记忆力减退,痴呆
⒎可能引起人的精神忧郁,
⒏引起有核巨红细胞性贫血(恶性贫血)
⒐脊髓变形,神经和周围神经退化
⒑舌、口腔、消化道的粘膜发炎 。
⒒若出现食欲不振、消化不良、舌头发炎、失去味觉等症状,便是缺乏维生素 B 12 的警讯
⒓小孩缺乏维生素B12的早期表现为精神情绪异常、表情呆滞、少哭少闹、反应迟钝、爱睡觉等症状,最后会引起贫血 。
13.增加患心脏病的危险.
维生素B12缺乏多因吸收不良引起,膳食维生素B12缺乏较少见 。膳食缺乏见于素食者,由于不吃肉食而发生维生素B12缺乏 。老年人和胃切除患者胃酸过少可引起维生素B12的吸收不良 。[1-3]
化妆品应用
维生素B12一般被称为造血维生素,具有肌肤再生的优越效果,细胞再生与造血都少不了它,是促进人体新陈代谢的重要成分 。
维生素B12是最新型的维生素,是所有维生素最后被发现的,分子构成最为复杂,人体中维生素B12含量会随着年龄的增加而逐渐减少,特别是女性因生理结构会减少的较快 。
轻松解决以下肌肤问题:
*肌肤疲惫、暗沉、干燥等问题肌肤;
*明显淡化因年龄增加所产生的细纹和皱纹;
*修护日晒后、秋冬干冷等引起的肌肤红肿、脱皮、疼痛;
*痘疤痕迹、蚊虫咬伤的疤痕、烧伤烫伤的疤痕;
*整型手术后使用,可以避免留下疤痕 。
主要用途医疗方面①用于治疗和预防维生素B12缺乏症 。
②用于胃切除或吸收不良综合症,维生素B12缺乏造成贫血的预防 。
③用于补充因消耗性疾病,甲状腺机能亢进,妊娠,哺乳等造成的维生素B12需求增加 。
④营养性和妊娠性贫血 。
⑤广节裂头绦虫病贫血 。
- 喝苦丁茶有没有副作用 苦丁茶的副作用有哪些
- 泳池派对有哪些 英雄联盟泳池派对有哪些英雄
- 公务员面试应注意哪些细节?
- 小学六一儿童节游戏有哪些?
- 2022最挣钱十大暴利行业 农村十大暴利行业有哪些
- 王勃是哪个时期的诗人? 王勃是哪个朝代的诗人?王勃的诗词作品有哪些?
- 虎成语有哪些
- 上海大型游戏公司 上海游戏公司有哪些
- 胎压故障灯亮的5个解决步骤有哪些 胎压故障灯是怎么回事
- 健康资料内容有哪些? 健康知识资料发放登记表怎么填
特别声明:本站内容均来自网友提供或互联网,仅供参考,请勿用于商业和其他非法用途。如果侵犯了您的权益请与我们联系,我们将在24小时内删除。
